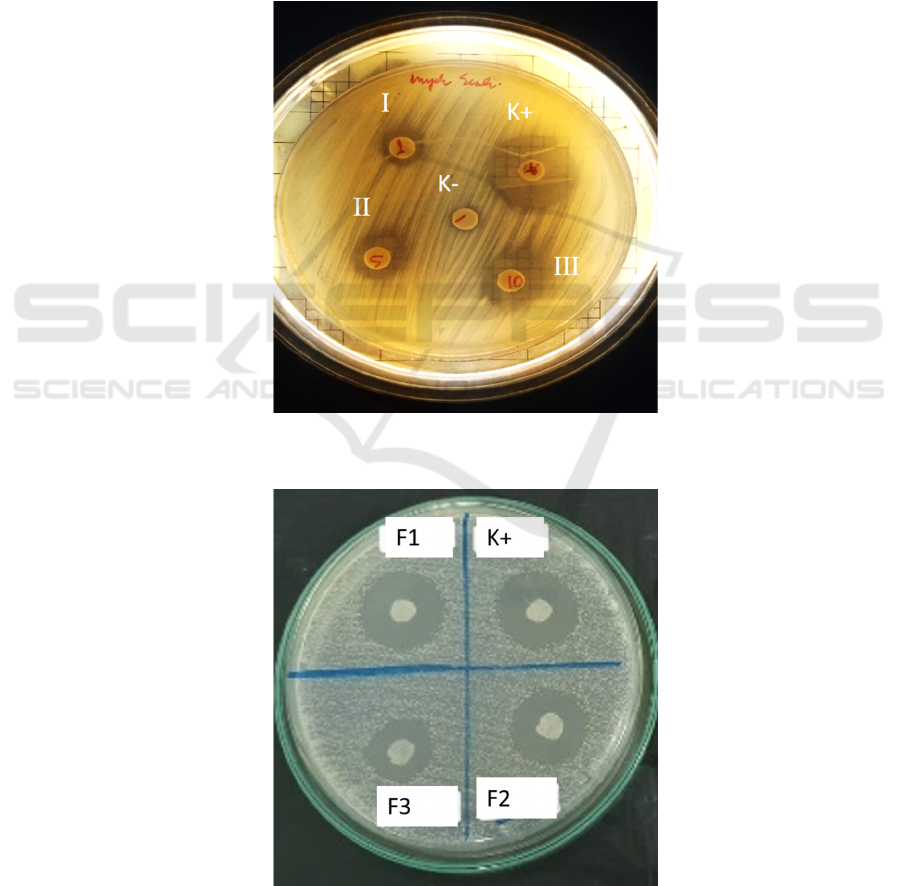

Formulation and Antibacterial Activity Test of Emulgel Containing
Citronella Oil (Cymbopogon Nardus L.) with Variaton of Gelling
Agent Carbomer
Dian Ermawati
*
, Raditya Weka Nugraheni, Nia Zuardina, Meilya Hayyu Saputri
Department of Pharmacy, Faculty of Health Science, University of Muhammadiyah Malang, Indonesia, Jalan
Bendungan Sutami 188A, Malang 65145, East Java, Indonesia.
Keywords: Antibacterial, Carbomer, Citronella Oil, Emulgel
Abstract: Citronella oil is the most volatile oil against Propionibacterium acnes. An emulgel preparation is made on a
carbomer base because it has better release properties of the active substance compared to other bases. The
research purpose was to determine the emulgel variation with carbomer base 0.5%, 1.0%, and 1.5%
containing 2% Citronella Oil (Cymbopogon nardus L.) on the physical, chemical characteristic and the
inhibition of Propionibacterium acnes bacteria growth. Emulgel with carbomer base made 3 formulations,
namely F1 (0.5%), F2 (1%), and F3 (1.5%) with citronella oil content of 2%. The physical characteristics of
the organoleptic, viscosity, homogeneity, dispersal, emulsion type, pH and stability (real time and freeze
thaw) tests were performed. Antibacterial testing using the Agar Well Diffusion method. The organoleptic
tests on FI (0.5%), FII (1%), and FIII (1.5%) were soft, white and has lemongrass odor. The results of one
way Anova statistic showed that there were not significantly different for pH, dispersion, stability (freeze
thaw and real time). The viscosity test was significantly different. The diameter of the inhibition zone of each
formula has a mean of formula 1 was 12.65 mm formula 2 was 11.58 mm, and formula 3 was 10.25 mm. The
conclusion of this experimentally is the effect of variations in emulgel based on 0.5%, 1.0%, and 1.5%
carbomers containing 2% Citronella Oil on the growth of Propionibacterium acnes bacteria has significant
difference which means that increasing carbomer levels it can significantly reduce the zone of antibacterial
inhibition.
1 INTRODUCTION
Acne or acne vulgaris is a dermatological disease that
affects about 80-85% of adolescents globally. Acne is
triggered by some species of skin flora such as
Propionibacterium acnes and Staphylococcus aureus
which are gram-positive bacillus bacteria found in
human skin microbiota (Lynn et al., 2016; Ishimura
et al., 2018). In people who do not get acne levels of
linoleic acid (LA) in sebum and sphingolipid levels in
the stratum corneum is higher than in patients with
acne (Jin and Lee, 2018).
In the treatment of acne until now, still using
antibiotic therapy, which is commonly used is
clindamycin because it is considered very useful for
treating microbial infections even though it only
lasted a few decades. The weakness of this antibiotic
that is antibiotic resistant can be transmitted between
individuals because the bacterium Propioni-
bacterium acnes can be resistant at certain times (Liu
et al., 2014; Walsh, Efthimiou and Dréno, 2016;
Yang et al., 2018). So it is necessary to replace active
ingredients that function as new antibiotics (Faleiro
and Miguel, 2013; Yang et al., 2018).
Lemongrass comes from the Poaceae family,
which has pharmacological potential for medicinal
plants. Studies show that citronella has antiviral,
antibacterial and antifungal activities. The main
chemical elements are Oxygen containing
monoterpenes, citronellal, geraniol, geranial,
citronellol and neral (Lertsatitthanakorn et al., 2010;
Shah et al., 2011; De Toledo et al., 2016).
Cymbopogon nardus oil (Citronella oil) is the
most active oil against Propionibacterium acnes that
has (MIC 0.005-0.3 ߤL / mL) (MBC 0.625 ߤL / mL)
(Sarlina, Razak and Tandah, 2017). The main target
of lemongrass oil is destroying bacterial cell walls
and damaging bacterial intracellular material that can
Ermawati, D., Nugraheni, R., Zuardina, N. and Saputri, M.
Formulation and Antibacterial Activity Test of Emulgel Containing Citronella Oil (Cymbopogon Nardus L.) with Variaton of Gelling Agent Carbomer.
DOI: 10.5220/0009130302230227
In Proceedings of the 2nd Health Science International Conference (HSIC 2019), pages 223-227
ISBN: 978-989-758-462-6
Copyright
c
2020 by SCITEPRESS – Science and Technology Publications, Lda. All rights reserved
223

cause bacterial death Propionibacterium acnes (Bota,
Martosupono and Rondonuwu, 2015). Gel dosage
forms are better used in the treatment of acne
compared to cream dosage forms because this is a gel
preparation with polar solvents that is easier to clean
from the surface after being used and does not contain
oils that can increase the severity of acne (Anggraini,
Rahmawati and Hafsah, 2013; Garg, Rath and Goyal,
2015).
The purpose of this study was to determine the
variation of emulgel with a carbomer base of 0.5%,
1.0%, and 1.5% containing 2% Citronella Oil to the
growth of Propionibacterium acnes bacteria in vitro.
2 METHODS
Materials
The research materials used are Citronella oil,
Carbomer, Sorbitan Monolaurate, Polysorbate 80,
Propylene glycol, Methylparaben, Propylparaben,
BHT, Aquadest (PT. Bratacho), and Triethanolamine
from (CV. Jayarindo Pratama), Propionibacterium
acnes bacteria and positive control of clindamycin gel
were obtained from the Microbiology Laboratory
Research Center of FKG Airlangga for testing the
activity of emulgel citronella oil.
Methods
The process of making an antibacterial type emulgel
(m / a) begins by developing a carbomer added with
heated aqua dest ad at a temperature of 700C in the
wait and waiting for the ad to expand and adding
Triethanolamine as an Alkalizing Agent ad reaching
a pH of 7, then carried out by mixing the entire oil
phase, namely: Propylparaben, Toluene Hydroxy
Butyl, Sorbitan Monolaurate, done in a glass beaker
(1) then mixed with the water phase, namely:
Methylparaben, Polysorbate 80, Propilengikol, and
water. The materials were melted using water bath
into one phase at 70C. After that, an emulsion was
made by mixing the oil phase into the water phase and
stirred homogeneously. Nearly at the end of the
emulsification process, the lemongrass oil added and
stirred homogeneously. The emulsion mixture has
formed mixed into a gelling agent (carbomer). After
the emulgel is formed, it is placed in a container that
has been prepared and ready for testing (Razak et al.,
2017).
3 RESULTS AND DISCUSSION
Organoleptic test results showed the characteristics of
white preparations, soft texture, and the distinctive
aroma of citronella oil. Physically, the emulgel
preparations appear homogeneous and free from
lumps of insoluble particles.
Table 1: Formulation of Citronella oil emulgel
Materials Function
Kontrol -
(%)
F1
(%)
F2
(%)
F3
(%)
Citronella Oil Active Ingredients - 2,0 2,0 2,0
Carbomer Gelling agent 0,5 0,5 1,0 1,5
Triethanolamine (TEA) Alkalizing Agent q.s q.s q.s q.s
Sorbitan Monolaurate (Span 20) Surfactants 2,34 2,34 2,34 2,34
Polysorbate 80 (Tween 80) Surfactants 2,66 2,66 2,66 2,66
Propylenglycol Humectant 5 5 5 5
Methyl paraben (Nipagin) Preservatives 0,1 0,1 0,1 0,1
Propyl Paraben (Nipasol) Preservatives 0,1 0,1 0,1 0,1
Butyl Hidroxy-toluene (BHT) Antioxidants 0,03 0,03 0,03 0,03
Purified Water Solvent Ad 100 Ad 100 Ad 100 Ad 100
Figure 1: The appearance of the emulgel preparation
HSIC 2019 - The Health Science International Conference
224
Citronella oil gives good results in the antibacterial
activity test of Propionibacterium acnes (Figure 2). It
can be seen from the figures that show that an increase
in the volume of citronella oil causes an increase in
the inhibition zone. Based on the results of the
antibacterial test of Citronella oil, the diameter at K +
is 19.00, 1 µl 7.00 5 µl 9.00 10 µl 11.00, this proves
that Citronella oil has antibacterial activity.
The results of measuring the diameter of the
emulgel inhibition zone carried out three times of
replication. The representative of the outcome, as
shown in figure 3 Based on the results of the
Citronella oil emulgel test, it was found that the
diameter of the positive control inhibition zone was
15.75 mm, formula 1 was 12.80 mm, formula 2 was
11.80 and formula 3 which is 10.40. The second
replication results showed that there is a positive
control of 15.80 mm, formula 1 is 12.55 mm, formula
2 is 11.40 mm, and formula 3 is 10.20 mm, the third
replication results are positive control namely 11.60
mm, formula 1 is 11.60 mm, formula 2 is 12.60 mm
and formula 3 is 10.15 mm.
Figure 2: The results of the antibacterial activity test for Citronella oil raw material. K+ was Erythromycin as positive control;
K- without Ctronella oil; I, II, and III contained 1μL, 5μL, 10μL Citronella oil, respectively.
Figure 3: The Results of antibacterial activity amulgel Citronella oil. K+ was clindamycin as positive control; K- without
Citronella oil; F1, F2, and F3 were formulation 1, 2, and 3, respectively.
Formulation and Antibacterial Activity Test of Emulgel Containing Citronella Oil (Cymbopogon Nardus L.) with Variaton of Gelling Agent
Carbomer
225

Table 2: Measurement results of inhibition zone diameter from Citronella oil emulgel
Replication
Inhibition zone diameter (mm)
Kontrol + Formula 1 Formula 2 Formula 3
1 15.75 12.80 11.80 10.40
2 15.80 12.55 11.40 10.20
3 15.60 12.60 11.55 10.15
Average± SD 15.72± 0.10 12.65± 0.13 11.58± 0,20 10.25± 0,13
Figure 4: Histogram of inhibition zone diameter from Citronella oil emulgel
Anova One-Way Test Results, showed a significance
value of 0,000 which means less than 0.05 (p <0.05)
so it can be said that there are significant differences
between variations in carbomer levels of 0.5%, 1.0%,
1.5 % containing Citronella Oil 2% on the growth of
Propionibacterium acnes bacteria in vitro, so it was
continued with the Honestly Significant Difference
(HSD) test to find out which data were different.
Honestly Significant Difference Test (HSD)
(Tukey HSD) shows a significance value of 0,000
which means less than 0.05 (p <0.05 and the results
obtained between formula 1 and formula 2 there is a
significant difference (p = 0,000) between formula 1
and formula 3 there is a significant difference (p =
0,000) between formula 2 and formula 3 there is a
significant difference (p = 0,000) so it can be
concluded that there is a significant difference
between variations in carbomer levels of 0.5%, 1.0%,
1.5% containing Citronella Oil (Cymbopogon nardus
L.) 2% on Propionibacterium acnes bacterial growth
in vitro due to the increase in carbomer levels
resulting in a decrease in inhibition zone diameter.
4 CONCLUSION
Based on the results of this study it can be concluded
that the effect of variations of emulgel with a
carbomer base of 0.5%, 1.0%, and 1.5% containing
Citronella Oil 2% on the inhibition of
Propionibacterium acnes bacteria there is a
significant difference which means the higher levels
of carbomer can significantly reduce the diameter of
the inhibition zone
REFERENCES
Anggraini, D., Rahmawati, N. and Hafsah, S. (2013)
‘Formulasi Gel Antijerawat dari Ekstrak Etil Asetat
Gambir’, Penelitian Farmasi Indonesia, 1(2), pp. 62–
66. Available at:
https://ejournal.unri.ac.id/index.php/FPFI/article/view/
1248 (Accessed: 7 November 2019).
Bota, W., Martosupono, M. and Rondonuwu, F. S. (2015)
‘POTENSI SENYAWA MINYAK SEREH WANGI
(CITRONELLA OIL) DARI TUMBUHAN
Cymbopogon nardus L. SEBAGAI AGEN
ANTIBAKTERI’, Prosiding Semnastek, 0(0).
Available at:
https://jurnal.umj.ac.id/index.php/semnastek/article/vi
12,65±0,13
11,58±0,20
10,25±0,13
0
2
4
6
8
10
12
14
16
Carbomer 0,5 % Carbomer 1,0 % Carbomer 1,5 %
Inhibition Zone Diameter (mm)
Carbomer usage (%)
HSIC 2019 - The Health Science International Conference
226

ew/548 (Accessed: 7 November 2019).
Faleiro, M. L. and Miguel, M. G. (2013) ‘Use of Essential
Oils and Their Components against Multidrug-
Resistant Bacteria’, Fighting Multidrug Resistance with
Herbal Extracts, Essential Oils and Their Components.
Academic Press, pp. 65–94. doi: 10.1016/B978-0-12-
398539-2.00006-9.
Garg, T., Rath, G. and Goyal, A. K. (2015) ‘Comprehensive
review on additives of topical dosage forms for drug
delivery’, Drug Delivery. Taylor & Francis, 22(8), pp.
969–987. doi: 10.3109/10717544.2013.879355.
Ishimura, M. E. et al. (2018) ‘Killed Propionibacterium
acnes enhances immunogenicity and tumor growth
control of a dendritic-tumor cell hybrid vaccine in a
murine melanoma model’, PLOS ONE. Edited by H.
Shiku, 13(10), p. e0205148. doi:
10.1371/journal.pone.0205148.
Jin, S. and Lee, M.-Y. (2018) ‘Kaempferia parviflora
Extract as a Potential Anti-Acne Agent with Anti-
Inflammatory, Sebostatic and Anti-Propionibacterium
acnes Activity.’, International journal of molecular
sciences. Multidisciplinary Digital Publishing Institute
(MDPI), 19(11). doi: 10.3390/ijms19113457.
Lertsatitthanakorn, P. et al. (2010) ‘Effect of Citronella Oil
on Time Kill Profile, Leakage and Morphological
Changes of Propionibacterium acnes’, Journal of
Essential Oil Research, 22(3), pp. 270–274. doi:
10.1080/10412905.2010.9700322.
Liu, J. et al. (2014) ‘Draft Genome Sequences of
Propionibacterium acnes Type Strain ATCC6919 and
Antibiotic-Resistant Strain HL411PA1’, Genome
Announcements, 2(4). doi: 10.1128/genomeA.00740-
14.
Lynn, D. et al. (2016) ‘The epidemiology of acne vulgaris
in late adolescence’, Adolescent Health, Medicine and
Therapeutics, p. 13. doi: 10.2147/AHMT.S55832.
Sarlina, S., Razak, A. R. and Tandah, M. R. (2017) ‘Uji
Aktivitas Antibakteri Sediaan Gel Ekstrak Daun Sereh
(Cymbopogon nardus L. Rendle) terhadap Bakteri
Staphylococcus aureus Penyebab Jerawat’, Jurnal
Farmasi Galenika (Galenika Journal of Pharmacy),
3(2), p. 50. doi: 10.22487/j24428744.0.v0.i0.8770.
Shah, G. et al. (2011) ‘Scientific basis for the therapeutic
use of Cymbopogon citratus, stapf (Lemon grass).’,
Journal of advanced pharmaceutical technology &
research. Wolters Kluwer -- Medknow Publications,
2(1), pp. 3–8. doi: 10.4103/2231-4040.79796.
De Toledo, L. et al. (2016) ‘Essential Oil of Cymbopogon
nardus (L.) Rendle: A Strategy to Combat Fungal
Infections Caused by Candida Species’, International
Journal of Molecular Sciences. Multidisciplinary
Digital Publishing Institute, 17(8), p. 1252. doi:
10.3390/ijms17081252.
Walsh, T. R., Efthimiou, J. and Dréno, B. (2016)
‘Systematic review of antibiotic resistance in acne: an
increasing topical and oral threat’, The Lancet
Infectious Diseases. Elsevier, 16(3), pp. e23–e33. doi:
10.1016/S1473-3099(15)00527-7.
Yang, M.-Y. et al.
(2018) ‘Low-dose blue light irradiation
enhances the antimicrobial activities of curcumin
against Propionibacterium acnes’, Journal of
Photochemistry and Photobiology B: Biology, 189, pp.
21–28. doi: 10.1016/j.jphotobiol.2018.09.021.
Formulation and Antibacterial Activity Test of Emulgel Containing Citronella Oil (Cymbopogon Nardus L.) with Variaton of Gelling Agent
Carbomer
227
